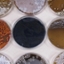

Gilles van Wezel
Hoogleraar Moleculaire biotechnologie
- Naam
- Prof. dr. G.P. van Wezel
- Telefoon
- 071 5274310
- g.wezel@biology.leidenuniv.nl
- ORCID iD
- 0000-0003-0341-1561

Gilles van Wezel, hoogleraar Moleculaire Biotechnologie, doet baanbrekend onderzoek naar de bacteriën die antibiotica produceren. Daarbij probeert hij zowel nieuwe antibiotica te vinden, als de productie van al bekende antibiotica te verbeteren. Veel antibiotica worden juist door bacteriën gemaakt. Deze antibiotica-producerende bacteriën vinden we in grond, zelfs in een lepeltje tuinaarde.
Meer informatie over Gilles van Wezel
Promovendi
Postdocs
Nieuws
-
 Subsidies voor nieuwe antibiotica, stedelijke veerkracht en gezondheidsimpact nanoplastics
Subsidies voor nieuwe antibiotica, stedelijke veerkracht en gezondheidsimpact nanoplastics -
 Bacteriën vol potentie: op zoek naar nieuwe antibiotica via de aan- en uitknoppen
Bacteriën vol potentie: op zoek naar nieuwe antibiotica via de aan- en uitknoppen -
 Slimmer zoeken naar antibiotica
Slimmer zoeken naar antibiotica -
 Meer dan miljoen euro voor twee onderzoeken naar oplossingen voor antibioticaresistentie
Meer dan miljoen euro voor twee onderzoeken naar oplossingen voor antibioticaresistentie -
 De oplossing voor antibioticaresistentie zou weleens onder onze voeten kunnen liggen
De oplossing voor antibioticaresistentie zou weleens onder onze voeten kunnen liggen -
 Van druppeltjes in de vriezer tot het begin van een krachtig nieuw antibioticum
Van druppeltjes in de vriezer tot het begin van een krachtig nieuw antibioticum -
 Gilles van Wezel stopt als WD IBL – Hubertus Irth is tijdelijke vervanger
Gilles van Wezel stopt als WD IBL – Hubertus Irth is tijdelijke vervanger -
 Prijs voor duurzaam ontwikkelen rozengeur
Prijs voor duurzaam ontwikkelen rozengeur -
 Door de kleinste lenzen kijken naar de grote wereld van de microbiologie
Door de kleinste lenzen kijken naar de grote wereld van de microbiologie -
 ‘Maar hoeveel bacteriën leven er dan op mijn handen?’ Micro-dag in foto’s
‘Maar hoeveel bacteriën leven er dan op mijn handen?’ Micro-dag in foto’s -
 Celwandloze bacteriën slurpen DNA uit omgeving op
Celwandloze bacteriën slurpen DNA uit omgeving op -
 ‘We hebben een gigantisch probleem als antibiotica niet meer werkt’
‘We hebben een gigantisch probleem als antibiotica niet meer werkt’ -
 Gilles van Wezel herbenoemd voor vier jaar
Gilles van Wezel herbenoemd voor vier jaar -
 Vier Leidse onderzoekers ontvangen ERC Advanced Grant
Vier Leidse onderzoekers ontvangen ERC Advanced Grant -
 Slapende antibiotica wakker maken met ERC Advanced beurs
Slapende antibiotica wakker maken met ERC Advanced beurs -
 Burgemeester Lenferink bezoekt Dutch Extract Library
Burgemeester Lenferink bezoekt Dutch Extract Library -
 Samenwerking van instituten tegen TBC in het Leidsch Dagblad
Samenwerking van instituten tegen TBC in het Leidsch Dagblad -
Leidse onderzoekers slaan handen ineen tegen tuberculose
-
 Deze elf Leidse bètaonderzoekers behoren tot de meest geciteerden ter wereld
Deze elf Leidse bètaonderzoekers behoren tot de meest geciteerden ter wereld -
 Frederic Lens: bruggenbouwer in biodiversiteitsonderzoek
Frederic Lens: bruggenbouwer in biodiversiteitsonderzoek -
 Kunstmatige intelligentie helpt zoeken naar nieuwe antibiotica
Kunstmatige intelligentie helpt zoeken naar nieuwe antibiotica -
 IBL coördineert project voor nieuwe medicijnen uit biodiversiteit van de zee
IBL coördineert project voor nieuwe medicijnen uit biodiversiteit van de zee -
 Omid Karami ontvangt de Krijn Rietveld Memorial Innovation Award tijdens feestelijke uitreiking
Omid Karami ontvangt de Krijn Rietveld Memorial Innovation Award tijdens feestelijke uitreiking -
 Omid Karami wint Krijn Rietveld Memorial Innovation Award
Omid Karami wint Krijn Rietveld Memorial Innovation Award -
 Cell Observatory en labs voorzichtig van start
Cell Observatory en labs voorzichtig van start -
 ENW-Groot-subsidies voor Leidse bètawetenschappers
ENW-Groot-subsidies voor Leidse bètawetenschappers -
 Leidse biologie gewaardeerd met grote NWO-beurzen
Leidse biologie gewaardeerd met grote NWO-beurzen -
 Slangengifklieren in het lab gekweekt
Slangengifklieren in het lab gekweekt -
 Altruïsme in bacteriën: kolonie verdeelt het werk
Altruïsme in bacteriën: kolonie verdeelt het werk -
 Gilles van Wezel bij EenVandaag en BNR over oeroude bacteriën uit mammoetpoep
Gilles van Wezel bij EenVandaag en BNR over oeroude bacteriën uit mammoetpoep -
 Hoe mammoetpoep bijdraagt aan antibioticaonderzoek
Hoe mammoetpoep bijdraagt aan antibioticaonderzoek -
 Bacteriën in plantenwortels bestrijden schimmelziekte
Bacteriën in plantenwortels bestrijden schimmelziekte -
 Zwaartekrachtsubsidie: ruim twintig miljoen voor duurzame gewassen
Zwaartekrachtsubsidie: ruim twintig miljoen voor duurzame gewassen -
 Europese samenwerking werpt licht op het ontdekken van industriële enzymen
Europese samenwerking werpt licht op het ontdekken van industriële enzymen -
 Nieuw antibioticum vernoemd naar Leiden
Nieuw antibioticum vernoemd naar Leiden -
 30 jaar en hoogleraar: het verhaal van Changsheng Wu
30 jaar en hoogleraar: het verhaal van Changsheng Wu -
 Unilever Research Prize voor masterstudent Lukas Kiefer
Unilever Research Prize voor masterstudent Lukas Kiefer -
 Nieuwe wetenschappelijk directeur voor het Instituut Biologie Leiden
Nieuwe wetenschappelijk directeur voor het Instituut Biologie Leiden -
 Gilles van Wezel in De Buitendienst over giftige medicijnen
Gilles van Wezel in De Buitendienst over giftige medicijnen -
 Wetenschap en bedrijfsleven werken samen aan alternatieven voor antibiotica
Wetenschap en bedrijfsleven werken samen aan alternatieven voor antibiotica -
 Op zoek naar betere medicijnen en behandelingen voor kanker
Op zoek naar betere medicijnen en behandelingen voor kanker -
 Zoektocht naar antibiotica kan makkelijker en sneller
Zoektocht naar antibiotica kan makkelijker en sneller -
 Met 6 miljoen vaart achter zoektocht naar nieuwe antibiotica
Met 6 miljoen vaart achter zoektocht naar nieuwe antibiotica -
 Nobelprijzen 2015: Leiden Science legt uit
Nobelprijzen 2015: Leiden Science legt uit -
 Nieuwe inzichten in de productie van antibiotica door bacteriën
Nieuwe inzichten in de productie van antibiotica door bacteriën -
 Forse investering voor gewasbescherming door microben
Forse investering voor gewasbescherming door microben -
 Gif van slangen en schorpioenen voor nieuwe antibiotica
Gif van slangen en schorpioenen voor nieuwe antibiotica -
 Slapende antibiotica wakker maken
Slapende antibiotica wakker maken -
 Meer dan 100x antibiotica in de klas
Meer dan 100x antibiotica in de klas -
 Groep 8 in de collegebanken van de Universiteit Leiden
Groep 8 in de collegebanken van de Universiteit Leiden -
 MicroSafari in Museum Boerhaave
MicroSafari in Museum Boerhaave -
MicroSafari, een interactieve audiotour over antibiotica
MicroSafari, een interactieve audiotour over antibiotica -
 Team Leiden ‘Antibiotica Gezocht’ wint Academische Jaarprijs
Team Leiden ‘Antibiotica Gezocht’ wint Academische Jaarprijs -
 Website Antibiotica Gezocht! online
Website Antibiotica Gezocht! online -
 Antibiotica gezocht! Team Leiden naar finale Academische jaarprijs
Antibiotica gezocht! Team Leiden naar finale Academische jaarprijs -
 Leiden Institute of Chemistry sleept vier NWO ECHO subsidies binnen
Leiden Institute of Chemistry sleept vier NWO ECHO subsidies binnen -
 De speurtocht naar meer antibiotica
De speurtocht naar meer antibiotica
In de media
-
 ‘We hebben een gigantisch probleem als antibiotica niet meer werkt’
‘We hebben een gigantisch probleem als antibiotica niet meer werkt’ -
 Samenwerking van instituten tegen TBC in het Leidsch Dagblad
Samenwerking van instituten tegen TBC in het Leidsch Dagblad -
 Gilles van Wezel bij EenVandaag en BNR over oeroude bacteriën uit mammoetpoep
Gilles van Wezel bij EenVandaag en BNR over oeroude bacteriën uit mammoetpoep -
 Gilles van Wezel in De Buitendienst over giftige medicijnen
Gilles van Wezel in De Buitendienst over giftige medicijnen -
 Website Antibiotica Gezocht! online
Website Antibiotica Gezocht! online
Oud-promovendi
-
 Janine Liedtke
Janine Liedtke -
 Hannah Augustijn
Hannah Augustijn -
 Isabel Nuñez Santiago
Isabel Nuñez Santiago -
 Chao Li
Chao Li -
 Nataliia V. Machushynets
Nataliia V. Machushynets -
 Mandy Hulst
Mandy Hulst -
 Renée Kapteijn
Renée Kapteijn -
 Helga van der Heul
Helga van der Heul -
 Doris van Bergeijk
Doris van Bergeijk -
 Alexander Kloosterman
Alexander Kloosterman -
 Chao Du
Chao Du -
 Zheren Zhang
Zheren Zhang -
 Sanne Westhoff
Sanne Westhoff -
 Xiansha Xiao
Xiansha Xiao -
 Anne van der Meij
Anne van der Meij -
 Wen Yang
Wen Yang -
 Ana Karenina Carmiol Ramijan
Ana Karenina Carmiol Ramijan -
 Mariana Avalos Garcia
Mariana Avalos Garcia -
 Lizah van der Aart
Lizah van der Aart -
 Rafaella Tassoni
Rafaella Tassoni -
 Boris Zacchetti
Boris Zacchetti -
 Mia Urem
Mia Urem -
 Maria Petrus
Maria Petrus -
 Dino van Dissel
Dino van Dissel -
 Changsheng Wu
Changsheng Wu -
 Le Zhang
Le Zhang -
 Hua Zhu
Hua Zhu -
 Giulia Mangiameli
Giulia Mangiameli -
 Katherine Celler
Katherine Celler -
 Magdalena Swiatek
Magdalena Swiatek
Hoogleraar Moleculaire biotechnologie
- IBL
- Microbial Sciences













